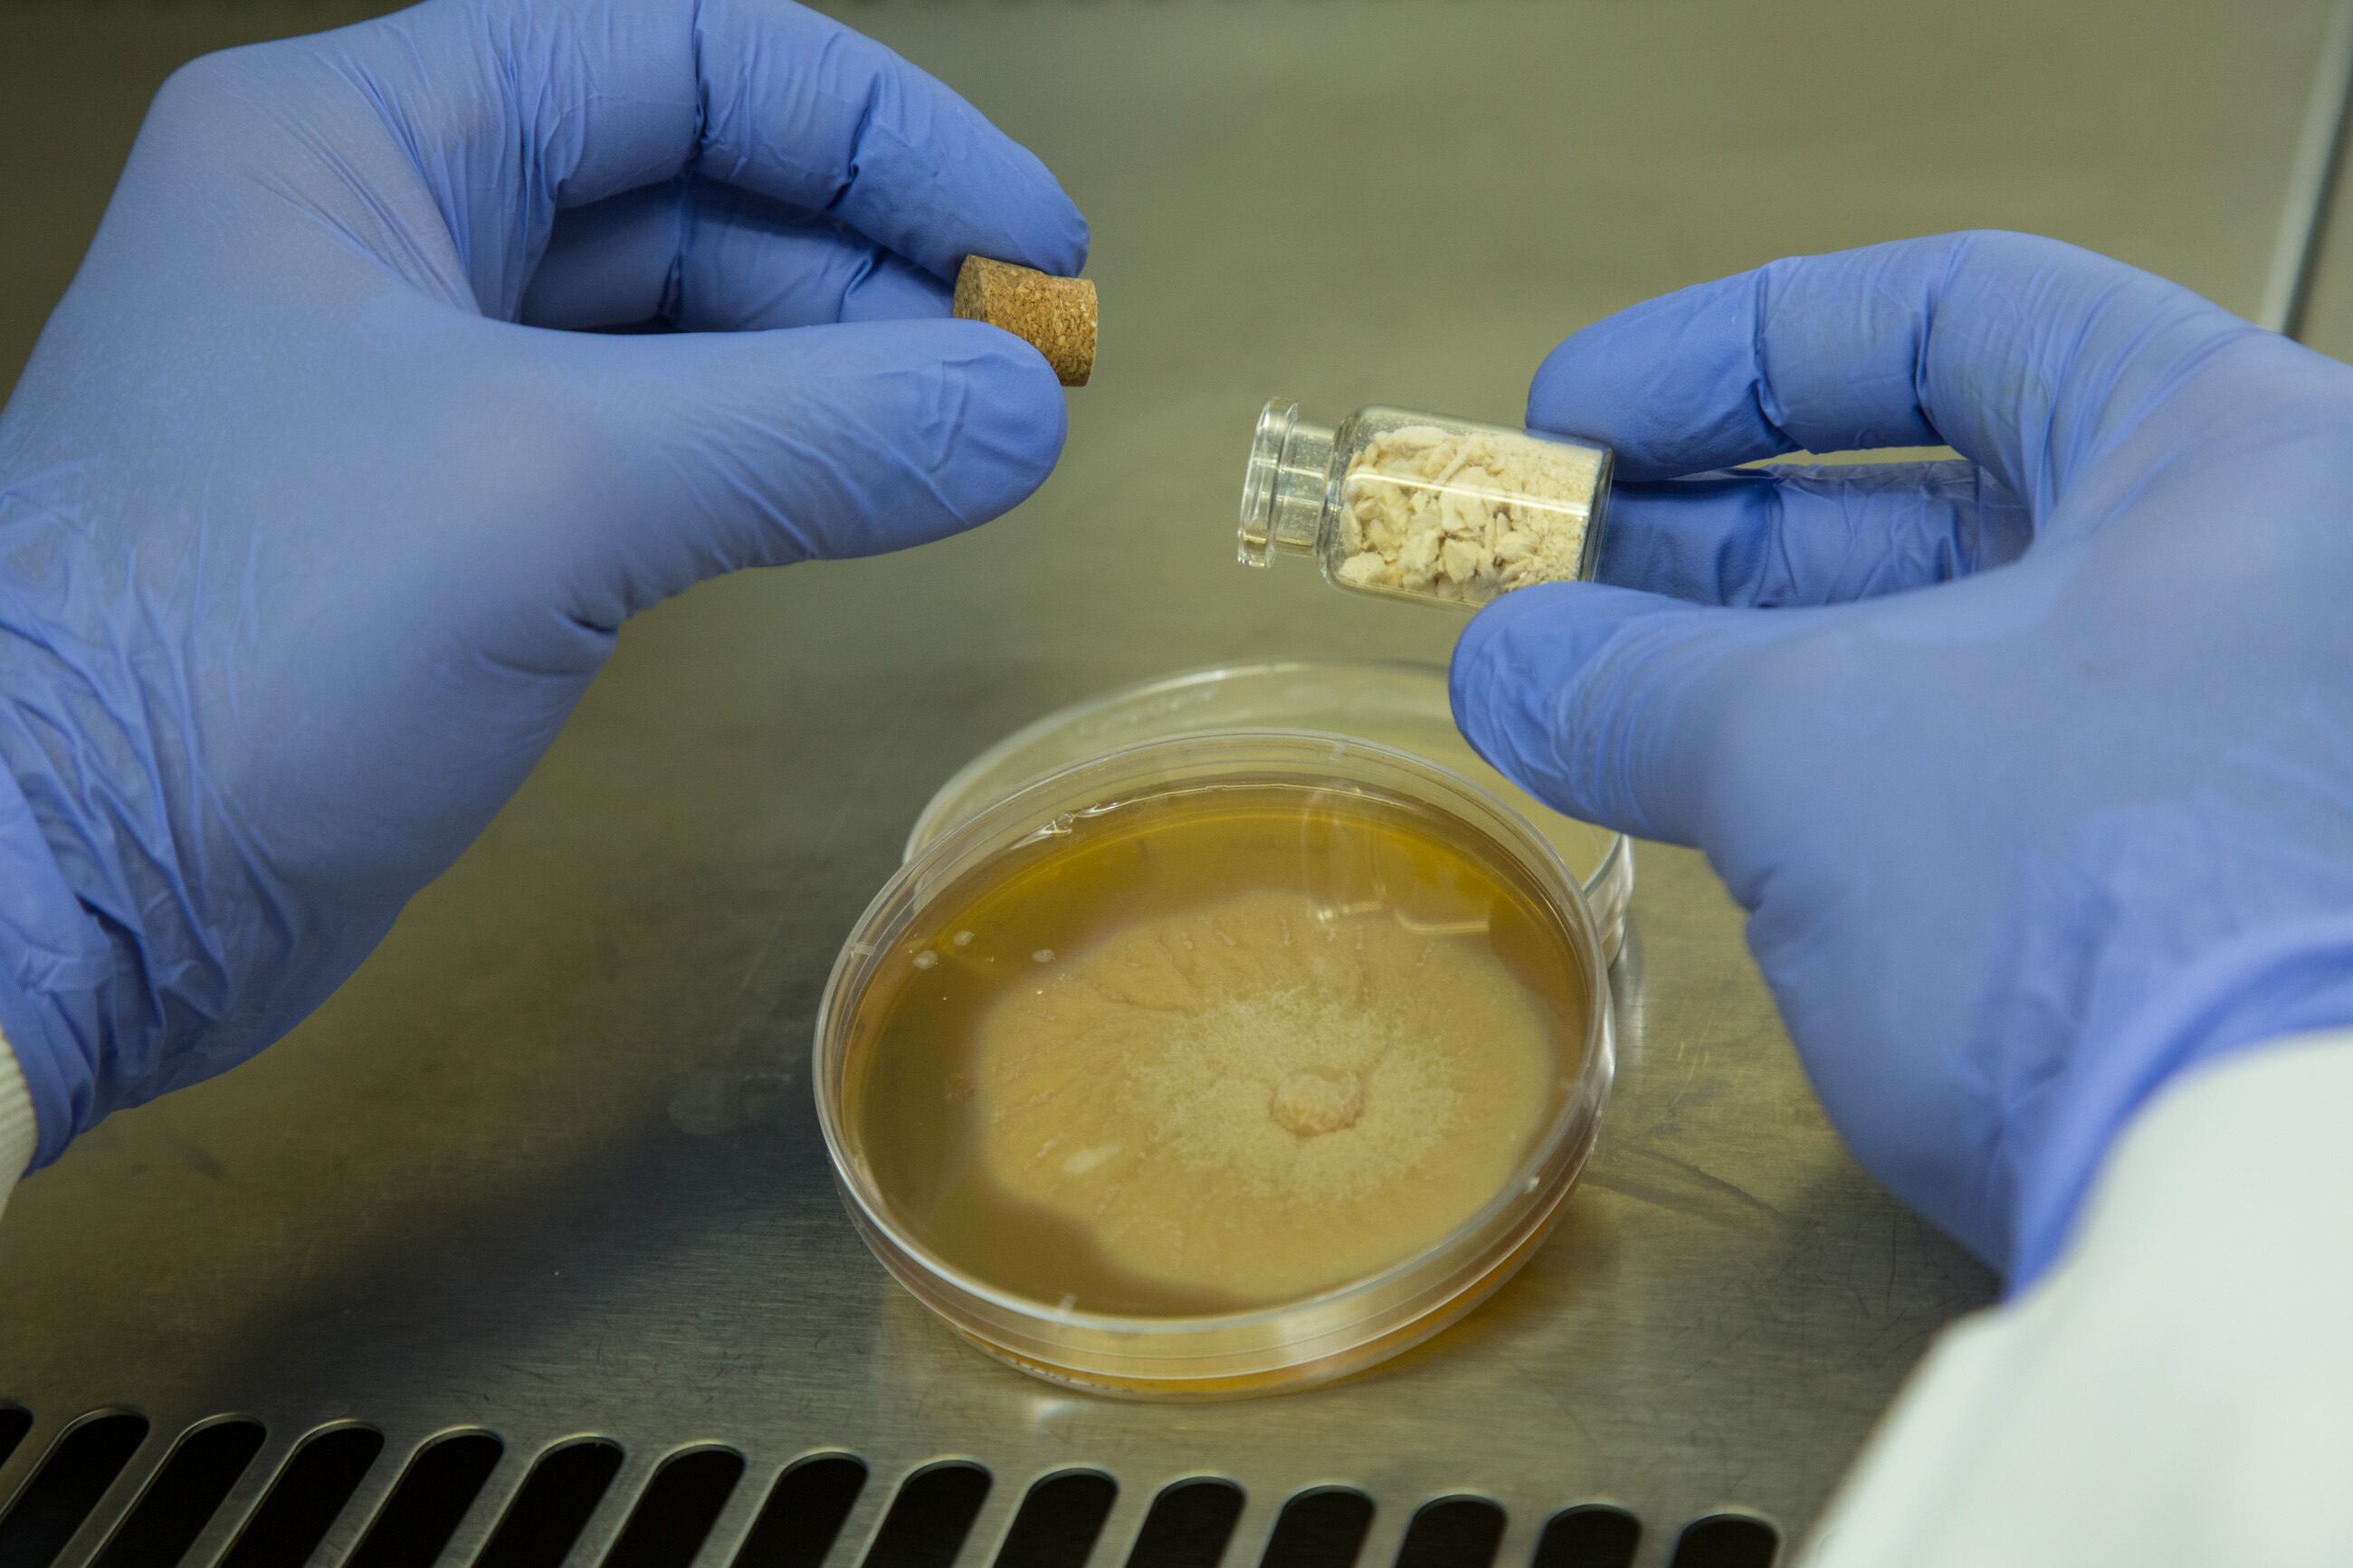

Horacio Acerbo is CEO and co-founder of Argentinian tech company EnyeTechnologies.
When he noticed the family of patents on Fusarium venenatum microfungus, better known under the brand name Quorn, had expired in 2010 but no-one had capitalized on this, he saw an opportunity.
“I’m not a food technician but I thought it would be great to have mushrooms in the home that can give me the same or better protein than a cow, fish or chicken,” Acerbo said.
EnyeTech, whose past projects include developing the Happy Places photo-sharing app for the Coca-Cola Company, therefore pitched the idea to Argentina’s National Institute of Industrial Technology (INTI), a branch of the Ministry of Production and Labor that helps national companies and researchers with R&D and NPD.
Specifically, it asked INTI to optimize the production process for the Fusarium venenatum fungus to make it more efficient, sustainable and cost-effective in both a food manufacturers' factory and a consumer's kitchen.
“Our main idea is to decentralize the production of protein in the world," said Acerbo.
INTI’s governing authority liked the idea and commissioned its researchers to start looking into it.
Martin Blasco, INTI researcher told FoodNavigator-LATAM: “The product is a filamentous fungus, which is the same as Quorn. [...] But we have a different plan and different approach.”
R&D ‘on demand’
INTI scientists started with the same process described in the expired patents and, through reverse engineering, identified ways to improve it, said Blasco.
The basic fermentation process starts with a solution of components – a carbon source, energy source, nitrogen source, and salt – that is ‘inoculated’ with

the fungus. Filaments called mycelia begin to grow in a mesh-like form floating in the liquid. This is then filtered, leaving an edible protein (the mycelia, dubbed ‘Kernel’ by EnyeTech) that resembles tuna in texture and is neutral in taste.
Blasco said: “We have optimized the culture medium to liquid form. I think that, in the end, we will use solid fermentation [technique] but at this moment we are using submerged fermentation.”
EnyeTech is now working on adding “a layer of Artificial Intelligence” to further optimize the process, with a focus on reducing inputs, while Argentina authorities have given INTI the green light to do further research with the company and develop more products using the mycoprotein.
Blasco could not comment on the intellectual property rights of the processes or products developed.
Quorn is an edible fungus or mycoprotein grown using a controlled fermentation process.
It was first launched as a plant-based protein on the UK market in 1985 by British company Marlowe Foods, a joint venture between Rank Hovis McDougall (RHM) and Imperial Chemical Industries (ICI). Acquisitions over the years have seen the brand change ownership to AstraZeneca, Montagu Private Equity, Premier Foods (among others) and Filipino company Monde Nissin, its current owner.
Quorn is not available in Argentina or neighboring countries.
B2B and B2C channels
Buenos Aires-based EnyeTech has a dual route-to-market strategy for Kernel.
The first is to establish joint licensing ventures with food companies, and it is already in talks with several major multinationals – both food manufacturers

and ingredient suppliers.
The second is to develop a kitchen appliance that allows consumers to grow around 300 g of protein each day. Acerbo likened the concept to a Nespresso machine where users insert coffee pods or printer with ink cartridges.
“We are not just making Quorn, we are working on a prototype for domestic use and production, and we have the idea to make it available for soup kitchens, canteens, shanty towns – wherever protein is needed,” said Acerbo.
“[This is] more efficient than having a cow in the field, then taking it to the slaughterhouse, then the butcher, then the consumer’s home. That takes a lot of energy and does harm to the ecosystem," he added.
“What we are doing takes 15% less water than a kilo of meat and has a carbon footprint 20 times smaller. You don’t need any logistics or packaging.”
The appliance is still at the development stage but the company plans to launch it at CES technology expo in January 2020.
‘Kernel has almost no taste. That’s a good thing for us’
The company said it is not trying to position Kernel as a like-for-like meat alternative.
Daniel de Piero, web and mobile developer at EnyeTech said: “We are not aiming to be a complete replacement for meat […] because that would reduce our market to vegans and vegetarians. This is another source of healthy protein with great nutritional value that people can adopt in their everyday diet.”
Acerbo echoed this. “We don’t aim to taste like meat, we can put [Kernel] in salty, sour or sweet compositions – muffins, cereals bars, sausages – and we can do it because it […] has almost no taste. That’s a good thing for us.”
The tech company is targeting the product globally.
“It would be weird to say ‘we will start a meatless protein revolution here in Argentina,” Acerbo said. “Argentinians eat more meat per person than anywhere else in the world. We want to be global.”
Kernel protein is cheaper than meat, which will increase accessibility; EnyeTech is currently looking at a cost of around US$2 per kilo. (It could not comment on the price of the home appliance.)
But do consumers really want to replace meat bought from their local supermarket or butcher with a cartridge of mycoprotein starter cultures that, instead of over?
Acerbo said he did not expect the concept to work in every country. “In some countries, it will have to be [a final product] in the supermarket, in others it could be at home.”
However, according to the entrepreneur, who struggled to find foods suitable for his child due to sensitivities to certain food additives, the concept allows people to take control of what they are eating “without being a specialist in food tech”.
It also ties in with other food movements, such as the trend for home brewing beer, he added.



